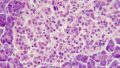

ねぇ、みんな!今日は心を広げる方法を紹介するよ~💕楽しんでね!
多重知能理論:あなたの「知恵」の種類を知ろう! 🌟
1. 多重知能の考え方とは?
長い間、知能はIQテストや学業の成績で測られてきたけど、ハーバード大学の心理学者ホワード・ガードナーが「知能とは一つの能力ではなく、様々な能力の集合体だ」と提唱したんだ!
今は、この考え方が学びや才能、問題解決の方法を再定義していて、いろんな場面で役立ってるよ! 🌈
2. ガードナーが言う知能の種類 🌟
ガードナーによると、知能にはいくつかのタイプがあるんだ。以下がそのリストだよ!
- 言語的知能
- 論理数学的知能
- 空間知能
- 身体運動的知能
- 音楽的知能
- 対人的知能
- 内面的知能
- 自然主義的知能
- ボーナス: 存在的知能(これは追加的なおまけ!)
3. 各知能の詳細 💡
3.1 言語的知能 📖
言語的知能は、言葉を使う能力を示してるんだ。上手にお話ししたり、文章を書いたり、物語を作るのが得意な人が多いよ。
- 強み:ライティング、読書、スピーチ、言語学習
3.2 論理数学的知能 ➗
この知能は、分析や数学的な問題を解く能力を反映してる。科学や論理的思考に関連しているよ。
- 強み:数学、コーディング、戦略ゲーム
3.3 空間知能 🎨
空間知能は、物事を立体的に考える力。例えば、絵を描いたり建物をデザインしたりする人に多いよ。
- 強み:絵画、建築、デザイン、ナビゲーション
3.4 身体運動的知能 🤸
これは体を使って表現したり、問題を解決する能力。スポーツやダンスが得意な人に多いよ。
- 強み:スポーツ、ダンス、演技
3.5 音楽的知能 🎶
音楽的知能は、リズムやメロディを感じたり、作ったりする力。音楽の才能がある人に多いかな。
- 強み:楽器演奏、作曲、音楽記憶
3.6 対人的知能 🤝
対人的知能は、他の人と良好にコミュニケーションをとる能力。感情を理解するのも得意だよ。
- 強み:コミュニケーション、リーダーシップ、共感
3.7 内面的知能 💭
内面的知能は、自分の感情や欲求を理解する力。深く考えることが得意な人に多いよ。
- 強み:自己反省、感情的知能、自立
3.8 自然主義的知能 🌱
自然主義的知能は、自然界のパターンを認識する能力。植物や動物、環境への感受性が高い人に向いてるよ。
- 強み:ガーデニング、生物学、動物のお手入れ
3.9 ボーナス: 存在的知能 🌌
存在的知能は、人生の深い疑問や宇宙について探求する能力。哲学や抽象的思考が得意な人に多いかも。
- 強み:哲学、心理学、倫理学
4. なぜ多重知能が重要なの? 🚀
ガードナーの理論は、知能を多様なスキルや思考の方法として捉え直すことを促進してるんだ。これは教育者にも影響を与えて、生徒一人ひとりに合った学習法を考慮するようにしているよ。それってすごく大事なことだよね! 😊
5. 最後に 🥳
「自分はどのタイプの知能が強いのかな?」って考えてみるのも面白いよ!みんなそれぞれ違った特性を持ってるからこそ、この世界は豊かなんだよね。だから、自分の得意な分野を見つけて、もっと楽しんで学んでいこう! 💖
そんな感じで、知能の多様性を理解することで、自分自身や他人をもっとよく知ることができるよ。これからの人生に活かしてみてね!

どんなタイプの知能があるのか、わかったかな? みんなそれぞれ得意なことがあるから、自分に合った方法で学んでいこうね!

コメント
そんなもんあるの?